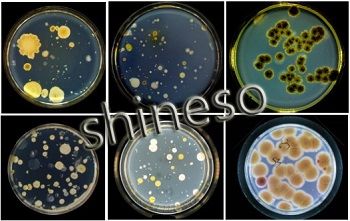
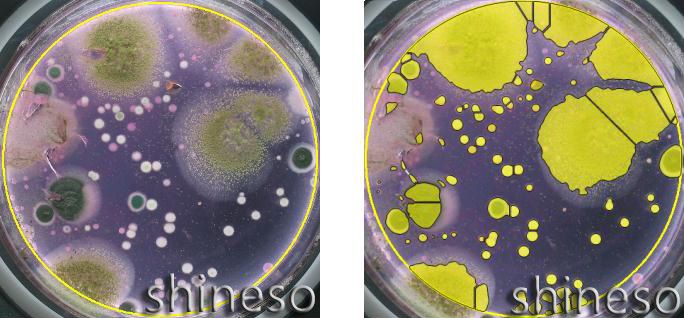
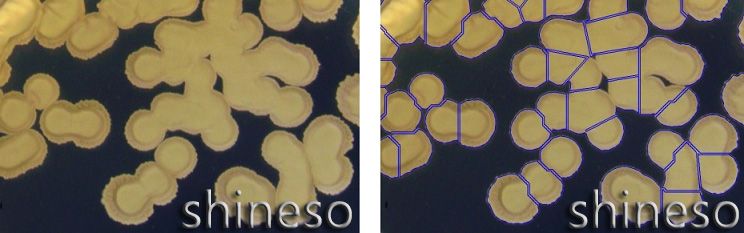
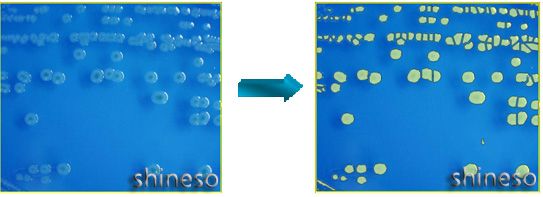

Czone 8是迅数科技推出的,具备审计追踪的高端智能抑菌圈测量及菌落计数仪,专为大中型企事业检测机构设计。
根据国家食品药品监督管理总局对食品、药品检测计算机信息系统要求而设计,以防篡改技术、测试环境-测试流程的智能重构技术、水印签章技术为核心,构建多层次、相互制约的安全管理保障体系,确保了系统的安全性、数据的完整、真实性,满足GMP审计追踪的要求。
Czone 8为全能检测型,全封闭暗箱、三色LED结构光、360度环绕漫射照明、晶锐悬浮式暗视野、千万像素摄像头搭配大光圈定焦镜头,保证了成像的锐利,同时满足食品、药品、环境、水质、抗菌防腐的软件分析模块,适合有实力的综合性检测机构。

保证系统安全、数据安全的架构设计
“系统管理员、数据管理员、操作员、复核员”四重系统架构,分设职能与权限,确保数据信息的安全、完整和真实。
系统管理员:负责创建、管理所有操作员与审核员的账户和登入密码。
数据管理员:负责全部测试数据的档案管理、封存、以及计算机的数据库管理。
操作员:负责培养皿菌落的测试、自检、修正、形成电子报告、递交审核、对审核通过后的文件进行报告打印。

审核员:负责对操作员递交的测试报告进行审核。
水印签章、防篡改、测试流程智能重构--实现有效的审计追踪
①多用户密码登入、电子签名、操作审核日期计算机生成;
②全部操作流程,如图片、稀释度、统计工具、所用参数、测试值、修正情况等,由计算机自动记录在数据库中,操作员无法进行改动;
③通过测试环境和流程的重现,复核员可以追溯操作员的全部操作。

全封闭照明
采用全封闭、宽光带照明技术,

符合人体工学的舷窗门设计,隔绝环境光的干扰,彻底消除杂散光在玻璃培养皿折射形成的光斑、光环现象,为精确菌落计数提供了必备的光影条件。
三色LED混合光源、色温调节
长寿命、低功耗、环保型三色LED混合光,通过暖色光和冷色光的配比,控制色温范围为3500K-8500k,拍出最真实的菌落色泽。

场景式照明
上光源:360度柔性混合光照明,

突显菌落的色泽和纹理,使菌落表面的皱折、凹陷、边缘的锯齿更富立体感;
下光源:晶锐悬浮式暗视野照明,可加大菌落与培养基之间的反差,清晰勾勒菌落轮廓。


一键智能六种模式
为方便实验员快速、准确地菌落计数
,综合常见平板类型,优化设计出六种智能模式:平面感模式、立体感模式、小菌落优先、大菌落优先、同色菌优先、培养基剔除模式,只需一键就完成菌落统计。
提高混杂菌落的统计精度
在菌落计数中,常见培养皿内同时混有形态、
色泽各异的细菌、霉菌、放线菌,尤其是霉菌菌落,质地松散,中心与边缘色泽变化大。迅数基于多层水平集框架模型分割算法,能较好解决多菌混杂的统计精度。
多重粘连下的菌落分割
基于拓扑理论的数学形态学分割方法,能快速准确地分割相互多重粘连的菌落。
3M微生物测试片一键式分析
3M™ Petrifilm™测试片上形成的菌落,细小、着色有深有浅,通过高保真镜头及1600万像素CMOS相机,能把微小的菌落凸显出来。专业软件模块可一键计数:3M™细菌总数测试片、金黄色葡萄球菌测试片、酵母测试片。大肠菌群测试片则需自动统计后,人工判别气泡。


解决疑难图像--基于水平集活动轮廓模型的图像分割算法
将水平集方法和活动轮廓模型结合起来,在极小化能量泛函的过程中活动轮廓不断逼近分割目标,直到活动轮廓线停止进化时分割完成。

红色菌落的可溶性色素扩散
半透明的致病菌菌落

黑线白底网格滤膜上的灰白菌落
螺旋菌落计数
螺旋平板

计数法则符合国家出入境检验检疫行业标准(SN/T 2098-2008)和美国FDA标准,支持指数模式、缓慢指数模式、均一模式、比例模式、草坪模式等。
Szone 抑菌圈多模式测量技术
抑菌圈测量常

采用钢圈双碟法、纸片法、琼脂打孔法,由于试验环节诸多因素,如:抗生素溶液浓度、培养基质量、PH值、试验菌菌龄、培养时间等,使得最后形成的抑菌圈有些轮廓清晰,也有边缘模糊或不整齐并伴有破裂现象。
迅数提供三种算法:自动检测、拟圆逼近、三点定圆,可适应不同类型抑菌圈的快速测量。
抗生素效价测定
抗生素效价测定要求抑菌圈图像边缘必须清晰, Czone 8配置的高清定焦镜头(150LP/mm)与1600万像素工业CMOS相机结合,确保了高清晰数字成像,为效价测定精度奠定了基础。依据中国药典2020版二剂量法、三剂量法及合并计算要求,重复性自检的相对误差小于0.01%;均匀性自检的相对误差小于0.1%;效价测量精度大于99.7%。

主要功能与技术指标
照明系统
1.光源
可见光:高亮三色LED结构光
254nm紫外:用于腔体消毒、紫外诱变
2.光路与照明控制
全封闭暗箱:消除环境杂散光干扰
上光源:场景式360°柔性无影光照明
下光源:晶锐悬浮式暗视野照明
上光、下光、双光、紫外,自由切换
色温可调(3500K-8500K)、光强可调
数字成像
高清工业定焦镜头:焦距8mm,分辨率150lp/mm
专业型CMOS相机:1/2.33英寸彩色CMOS传感器、1600万像素、C-Mount、USB3.0
菌落分析模块
1.基本菌落计数功能
平皿类型:倾注、涂布、膜滤、螺旋平皿、3M纸片
一键智能计数(6模式):平面感模式、立体感模式、小菌落优先、大菌落优先、同色菌优先、培养基剔除模式
全皿菌落统计:菌落总数统计,并按25档尺寸分类显示
区域选择统计:可选择圆形、矩形、任意圈定区域进行统计
直径分类统计:设置直径范围,统计特定大小的菌落
鼠标点击统计:快速标记、添加菌落,适合培养皿边缘菌落的计数
菌落粘连分割:自动分割相互粘连的菌落,链状菌落由用户选择分割或不分割
2.高级菌落统计功能
螺旋菌落统计:根据FDA标准自动计数螺旋平板,支持指数模式、缓慢指数模式、均一模式、比例模式、草坪模式等。兼容美国SBI、西班牙IUL螺旋接种仪。支持出入境检验检疫行业标准SN/T 2098-2008
动态调节统计:可对统计结果进行动态调节修正,快速获取**统计效果。
偏差预估统计:适用于菌落颜色多且复杂的情况。
水平集多模型算法:搜索运算,获取**图像分割效果,适应培养基背景变换
特定菌落统计:根据菌落色泽、大小、轮廓特征,识别特定菌落
反式统计:适合菌落类型极其复杂而培养基背景均匀
杂菌、杂质剔除:根据形态、尺寸、颜色的区别,进行自动杂菌、杂质剔除
多色自动聚类:选择颜色匹配精度,根据色泽差异,分类统计全皿彩色菌落
3.网格滤膜与3M测试片
黑色实线网格一键统计
3M细菌总数测试片、3M金黄色葡萄球菌测试片:一键统计
3M大肠菌群测试片、3M大肠杆菌/大肠菌群快速测试片:一键统计+人工选择
4.微生物限度分析工具
培养基适用性检查(适应中国药典2020版)
控制菌检查-菌落形态
5.专项分析
防霉检测:定量分析防霉等级
串联统计:适合培养基背景不均匀的复杂菌落
并联统计:适合多孔板、OPKA、SBA分析
6.高级工具
网格清除:消除滤膜网格背景干扰
人工计数修正:添加或删除菌落
排除污染区域:鼠标勾勒任意污染区域,自动剔除污染区域的菌落数
背景文字消除:自动消除记号笔干扰
背景斑纹去除:自动消除培养皿污渍干扰
人工粘连分割:手动分割多重粘连菌落
参数自动换算:培养皿直径、样本稀释度输入,实现自动换算
文字、图形标注:各类绘图工具和中英文文字嵌入
7.标定与测量
仪器标定:仪器自带标定、人工修正标定
一键式快速测量:一键测定大菌落,适合真菌、放线菌的单菌落分析
全皿自动测量:全皿菌落的等效直径、面积、长短径、周长、圆度分析
手动精确测量:长度、角度、弧度、面积、弧线、任意曲线
数据安全与管理
1.“系统、数据、操作、复核”四重系统架构,分设职能与权限,确保数据信息的安全、完整和真实
系统管理员(最高层):负责创建、管理所有操作员与审核员的账户和登入密码。确保操作员与操作员之间、操作员与审核员之间的账户隔离与数据隔离。
数据管理员(副高层):负责全部测试数据的档案管理、以及计算机的数据库管理。封存所有审核通过的测试报告或将原始图片、测试数据备份、导出,保证了数据的完整性、安全性。
操作员:负责培养皿菌落的测试、自检、修正、形成电子报告、递交审核、对审核通过后的文件进行报告打印。
复核员:负责对操作员递交的测试报告进行审核。核查数据输入与处理过程,但无权修改;对存疑报告作“审核退回”处理,要求操作员重新测试;对“审核通过”的报告将**性存档,无论审核员还是操作员都无权再删除,以确保数据的原始性和真实性。
2.数据存储与导出
以电子数据为主,记录:样本来源、编号、稀释度、平皿图片、识别效果、计数值、所用统计工具、参数设置、修正情况,确保记录信息完整。
满足质量审计,存储的电子数据能以PDF或Excel格式打印输出
3.水印签章技术、防篡改技术、测试流程智能重构技术,实现有效的审计追踪
4.防篡改技术
采用多用户登入管理,所有操作员、审核员的名字,被系统自动记录在操作流程和测试报告中;所有操作日期、审核日期,由计算机自动生成,避免错填或伪造。
全部操作流程,包括:菌落图片、培养皿尺寸、样本稀释度、统计工具、所用参数、测试所得的菌落总数、自检修正后的菌落总数等,由计算机自动记录在数据库中,操作员无法进行改动,为后续审计提供全部真实数据。
5.水印签章技术
“审核通过”的测试报告会自动生成操作员和审核员的账户电子签名,并在报告上加印防伪的“审核通过”水印签章。
6.测试流程的智能重构技术
“复核员”打开“等待审核”的测试记录,计算机自动复原操作员的全部流程和测试环境,包括:当时所测的培养皿图片、测试结果、培养皿尺寸、样本稀释度、采用的统计工具及所用参数、测试所得的菌落总数、修正情况……
通过测试环境和测试流程的重现,复核员可以追溯操作员的全部操作,复核测试结果的准确性,达到审计追踪目的。
抑菌圈分析模块
1.Szone 抑菌圈多模式测量技术
自动检测:基于抑菌圈轮廓的精确边缘检测,适合边缘清晰、圆形抑菌圈
拟圆逼近:基于抑菌圈轮廓的圆形拟合逼近,适合边缘破裂、非标准圆形抑菌圈
人工检测:鼠标点击抑菌圈边缘上三点成圆,适合边缘模糊的抑菌圈
2.抗生素效价测定
一剂量法效价检测:适合美国药典
二剂量法、三剂量法及合并计算:适合中国药典2020版
重复性自检:相对误差≤0.01%、重复测量精度 ≤0.002mm
均匀性自检:相对误差≤0.1%
台间测量差异≤0.2%
3.舒巴坦敏感β-内酰胺酶检验
纯水验证:根据(A)、(B)、(D)产生抑菌圈,D-C≧3, B-A≦3 ,判定系统成立
自动检测三个平行样本的(A)、(B)、(C)、(D)抑菌圈,并数据导入
自动计算平行试验平均值,智能判别结果的阴阳性。
无效报告自动预警
数据库模块
数据存储、智能查询
数据导出:统计结果以Excel表导出
数据安全:操作者使用权限,数据修改权限设置
仪器规格与配置
Czone 8菌落计数及抑菌圈测量仪主机1台
菌落分析软件、自动抑菌圈测量软件、抗生素效价测定软件、舒巴坦敏感β-内酰胺酶检验软件
品牌商务台式电脑:双核CPU/4G内存/1T硬盘/DVD光驱/21.5"高清屏,Windows 7系统以上